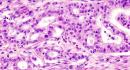
details

Trending News
Elections 2025States / The Hindu

Hypoxia rewires membrane lipids, drives pancreatic cells to move: IIT-Bombay study
25 Nov 2025 11:30 am
 23 C
23 C
Hypoxia rewires membrane lipids, drives pancreatic cells to move: IIT-Bombay study